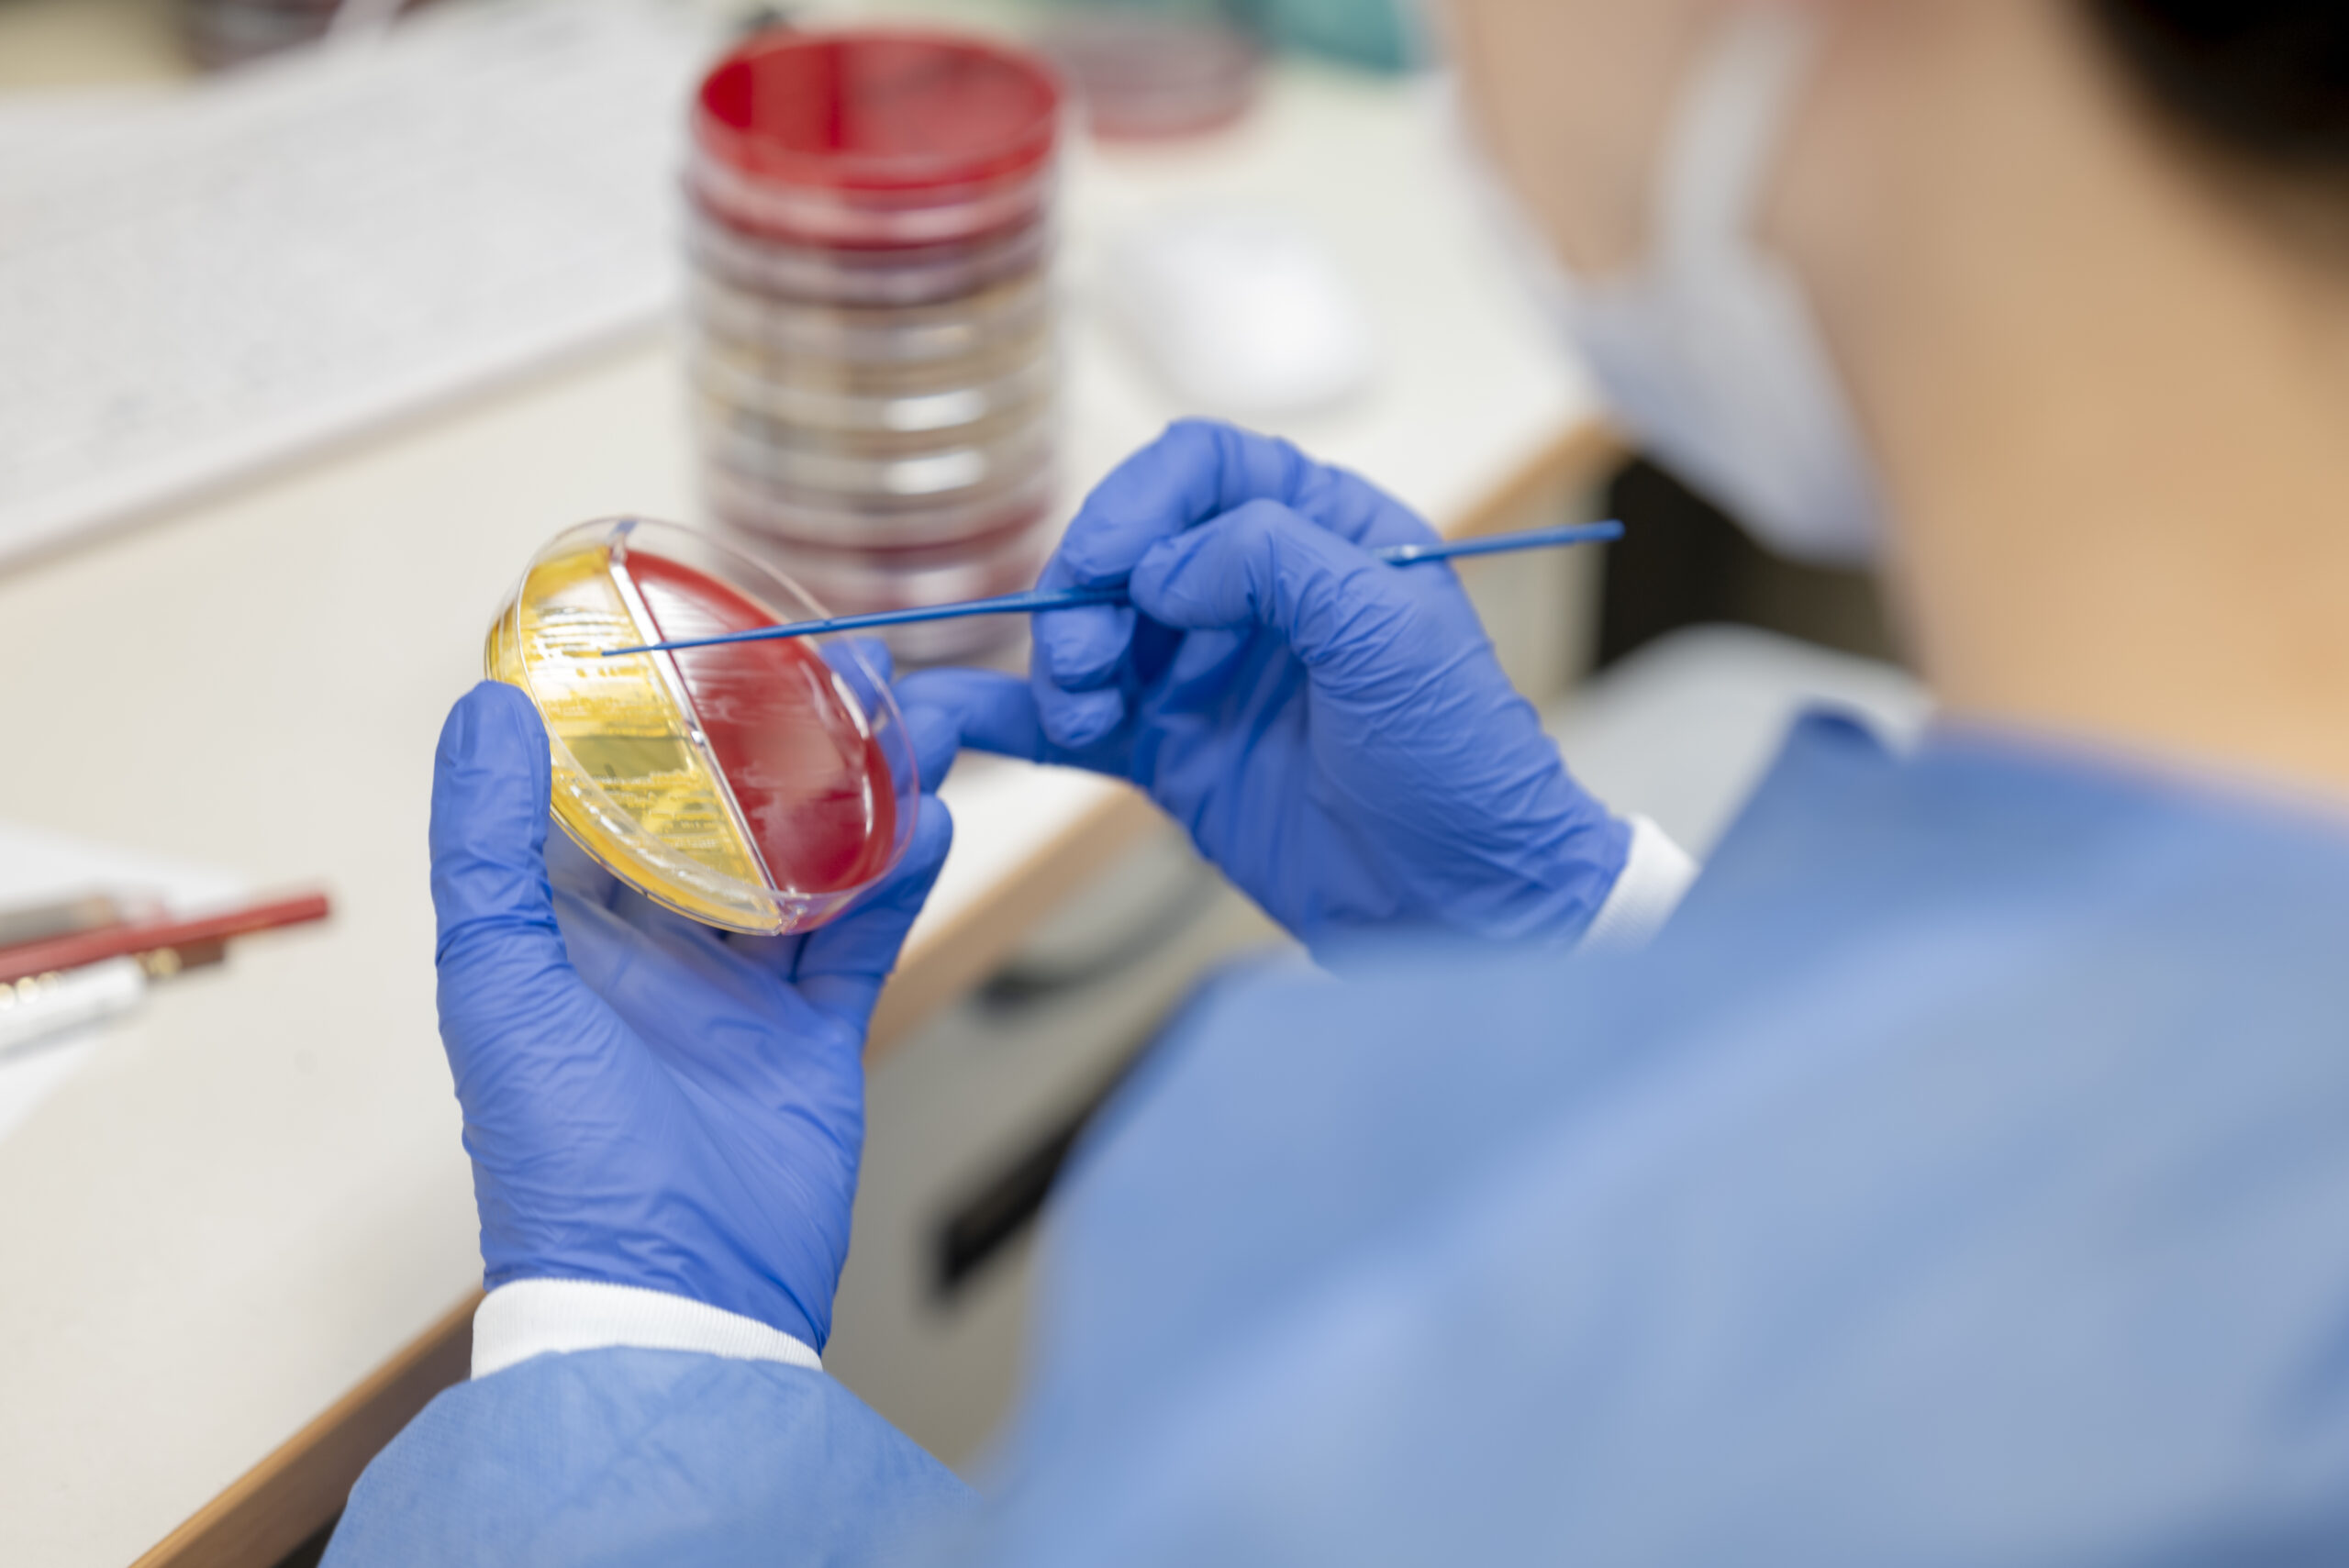

目次インデックス
理念
OUR PHILOSOPHY
高い技術力と人間力を結集し
一期一会に心を籠めて最高のパフォーマンスを発揮する
私たちは1人1人が意識して技術を洗練し、チームの一員として最高の技術を提供します。
私たちは高い倫理観を意識し、連携し日々取り組みます。
| 技術部の活動を発信しています。技術部は、放射線技師・臨床工学士・薬剤師・検査技師・リハビリセラピスト・栄養士・調理師の6部署の集まりです。日々の取り組みを随時発信していきますので、ぜひご覧ください。
[関連リンク] |
![]() |
技術部の目標
私たちの役割を考え
技術・人間力を磨き
一歩先へ進む集団であり続ける
~そして未来へつなぐ
私たち1人1人では何も解決できません。1人1人が連携し、任された役割を責任もってやり遂げることでチームが1歩、1歩前に進み解決に近づきます。時には傾聴し、時にはリーダとなりチームの中で力を発揮します。